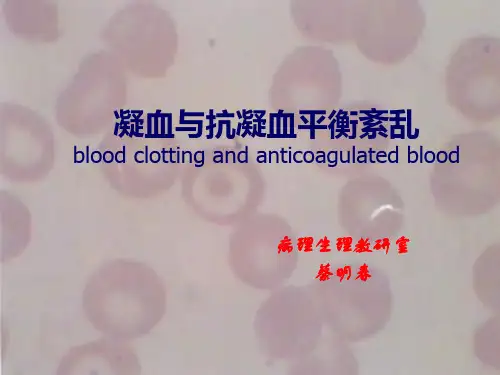

病理生理DIC
- 格式:doc
- 大小:151.50 KB
- 文档页数:5




dic名词解释病理生理学
病理生理学是研究疾病过程中发生的生理变化的学科。
它结合了病理学和生理学的知识,探究疾病如何影响机体的正常生理功能。
病理生理学研究的主要内容包括以下几个方面:
1. 疾病的病理生理机制:研究疾病发生发展的生理变化,探究病因与机体反应之间的关系。
通过研究疾病的病理生理机制,可以揭示疾病的发病原因,为临床治疗提供理论依据。
2. 疾病的生理功能改变:研究疾病对机体生理功能的影响,包括代谢、呼吸、循环、免疫等方面的变化。
通过了解疾病对生理功能的影响,可以更好地理解患者的临床表现,并进行相应的治疗。
3. 疾病的诊断与监测:研究疾病对生理指标的影响,探索通过监测机体的生理变化来诊断和监测疾病的方法。
通过研究疾病的病理生理特征,可以开发出有效的诊断方法和监测指标。
总之,病理生理学是一门综合性学科,通过研究疾病的生理变化,揭示疾病的发病机制,为临床诊断和治疗提供理论基础,对于预防、诊断和治疗疾病具有重要的意义。


弥散性血管内凝血(DIC)考纲:九、弥散性血管内凝血(DIC)1.病因和机制2.影响因素3.功能与代谢改变一、定义弥散性血管内凝血(DIC)——是指在某些致病因子的作用下,大量促凝物质入血,凝血因子和血小板被激活,使凝血酶增多,微循环中形成广泛的微血栓(高凝状态),继而因凝血因子和血小板大量消耗和继发性纤维蛋白溶解功能增强(低凝状态),机体出现以止、凝血功能障碍为特征的病理生理过程。
主要临床表现为出血、休克、器官功能障碍和微血管病性溶血性贫血等,是一种危重的综合征。
二、病因三、发病机制(一)DIC的发生1.组织损伤——组织因子(TF)释放,外源性凝血系统激活,启动凝血过程。
富含TF的组织有前列腺、肝、脑、肺、胰等2.血管内皮细胞损伤——凝血、抗凝调控失调3.血细胞破坏(1)红细胞大量破坏(2)白细胞的破坏或激活(3)血小板被激活4.促凝物质进入血液如:急性坏死性胰腺炎时,大量胰蛋白酶入血、蛇毒,如锯鳞蝰蛇毒、肿瘤细胞、羊水……组织损伤后导致DIC的机制主要是A.PC——蛋白酶C——抗凝物质B.AT- Ⅲ——抗凝血酶Ⅲ——抗凝物质C.肝素——抗凝物质D.TFPI——组织因子途径抑制物——抗凝物质E.TF——组织因子——启动外源性凝血途径『正确答案』E引起DIC的常见原因不包括A.恶性肿瘤B.严重创伤C.严重感染D.异型输血E.蛇咬伤中毒『正确答案』E(二)DIC的发展发生机制主要表现实验室检查高凝期凝血系统激活→凝血酶↑→微血栓血液处于高凝状态·凝血时间↓·血小板粘附性↑消耗性低凝期凝血因子和血小板因消耗而减少血液处于低凝状态,有出血表现·血小板计数↓·凝血酶原时间↓·纤维蛋白原含量↓·出血时间↑·凝血时间↑继发纤溶亢进期纤溶系统激活→产生大量纤溶酶;→纤维蛋白(原)降解产物形成明显出血·FDP↑·凝血酶时间↑·3P试验(+)DIC时,血液凝固性表现为A.凝固性增高B.凝固性降低C.凝固性先增高后降低D.凝固性先降低后增高E.凝固性无变化『正确答案』C急性DIC过程中,各种凝血因子均减少,其中减少最为明显的是A.纤维蛋白原B.凝血酶原C.Ca2+D.FⅫE.FⅤ『正确答案』A四、影响因素——DIC诱因(一)单核吞噬细胞系统功能受损(二)肝功能严重障碍(三)血液高凝状态(四)微循环障碍(五)医源性因素(一)单核吞噬细胞系统功能受损>>生理作用:单核吞噬细胞系统具有吞噬功能,也可清除纤溶酶、纤维蛋白降解产物(FDP)等。

DIC 病理生理学(二)
DIC 病理生理学是一种严重的出血性疾病,其病理生理学特点主要表现在以下几个方面:
1. 血小板减少:DIC 病理生理学的特点之一就是血小板减少,这是由于血小板被过度消耗和破坏所致。
血小板减少会导致出血倾向,严重时会导致内脏出血。
2. 凝血酶形成:DIC 病理生理学的另一个特点是凝血酶形成。
当机体遭受到严重的创伤或感染时,会激活凝血系统,导致凝血酶的形成。
凝血酶会使血液凝固,形成血栓,导致血管阻塞。
3. 纤维蛋白溶解:DIC 病理生理学的第三个特点是纤维蛋白溶解。
当机体遭受到严重的创伤或感染时,会激活纤维蛋白溶解系统,导致纤维蛋白溶解。
纤维蛋白溶解会使血管壁变薄,导致出血。
4. 微循环障碍:DIC 病理生理学的第四个特点是微循环障碍。
当机体遭受到严重的创伤或感染时,会导致微循环障碍。
微循环障碍会使血液流动不畅,导致组织缺氧,加重病情。
5. 炎症反应:DIC 病理生理学的最后一个特点是炎症反应。
当机体遭受到严重的创伤或感染时,会激活炎症反应,导致体内炎症因子的释放。
炎症反应会加重病情,导致器官功能障碍。
综上所述,DIC 病理生理学是一种严重的出血性疾病,其病理生理学特点主要表现在血小板减少、凝血酶形成、纤维蛋白溶解、微循环障碍和炎症反应等方面。
了解这些特点对于诊断和治疗 DIC 病理生理学具有重要意义。

DIC形成机制
DIC是指弥散性血管内凝血(Disseminated Intravascular Coagulation),是一种病理性凝血过程,主要表现为微血管内血栓形成和消耗性凝血因子的大量消耗。
DIC形成机制复杂,一般认为是以下几个方面的因素共同作用的结果:
1. 血管内皮细胞损伤:血管内皮细胞是血管的内层,对血管的稳定性和正常的血液流动起着至关重要的作用。
当血管内皮细胞受到损伤时,会释放出一些细胞因子和凝血因子,促进血小板的聚集和凝血的发生。
2. 炎症反应:炎症反应是机体对外界刺激的一种非特异性反应,包括炎症细胞的激活、炎症介质的释放等。
炎症反应可以引起血管内皮细胞的损伤和血小板的聚集,从而促进DIC的发生。
3. 肿瘤坏死因子(TNF):TNF是一种重要的炎症介质,可以引起血管内皮细胞的损伤和血小板的聚集,从而促进DIC的发生。
4. 血液凝固系统的失衡:DIC的发生与血液凝固系统的失衡密切相关。
当机体受到某些刺激时,凝血系统会被激活,产生大量的凝血因子和血小板聚集,形成血栓。
但是,如果凝血系统的平衡被打破,会导致大量的凝血因子和血小板聚集,形成微血管内血栓和消耗性凝血因子的大量消耗,从而
引起DIC。
DIC的形成机制非常复杂,涉及到多种因素的相互作用。
了解DIC的形成机制对于预防和治疗DIC具有重要的意义。

弥散性血管内凝血(DIC ):是指由于某些致病因子的作用,凝血因子和血小板被激活,大量促凝物质入血,凝血酶增加,进而微循环中形成广泛的微血栓。
微血栓形成中消耗了大量凝血因子和血小板,继发性纤维蛋白溶解功能增强,导致患者出现明显的出血、休克、器官功能障碍和溶血性贫血等临床表现。
DIC的原因和发病机制1组织因子释放入血,启动外源性凝血系统2血管内皮细胞损伤,凝血、抗凝调控失调3血细胞大量破坏4其他促凝物质进入血液1红细胞破坏←血型不符输血、疟疾、PNH--阵发性睡眠性血红蛋白症①释放大量ADP,促进血小板粘附,聚集; 膜磷脂浓缩凝聚大量凝血因子凝血2白细胞的破坏和激活。
原因:内毒素刺激,白血病治疗。
机制:释放TF样物质,启动外凝系统3血小板激活。
原因:内毒素、免疫复合物、内皮受损。
机制:激活、粘附、聚集急性坏死性胰腺炎,胰蛋白酶激活凝血酶原蛇毒激活凝血酶原,促进DIC发生肿瘤细胞分泌促凝物质激活FⅩ羊水含有组织因子样物质抗原抗体复合物活化FⅫ、血小板DIC时机体功能、代谢变化1出血2器官功能障碍3休克4贫血皮肤瘀斑,紫癜。
呕血,黑便咯血,血尿,鼻出血和阴道出血出血机制(一)凝血物质被消耗而减少(二)纤溶系统激活(三)FDP、FgDP形成。
FDP:纤溶酶水解纤维蛋白原(Fbg)和纤维蛋白(Fbn)产生的片段,通称为纤维蛋白(原)降解产物(FDP,FgDP)。
功能:妨碍纤维蛋白单体聚合,抗凝血酶,降低血小板的粘附,聚集和释放,加重出血倾向。
微血管内微血栓大量形成→器官缺血、缺氧→组织坏死→功能衰竭肾上腺---沃弗综合征DIC时,红细胞粘着、悬挂在纤维蛋白性微血栓网上,随血流冲击破裂而导致引起的贫血,称为微血管病性溶血性贫血。
外周血涂片中可见一些形态特殊的红细胞,称裂体细胞,是诊断DIC的重要参考指标。

医学dic名词解释DIC,即弥散性血管内凝血(Disseminated Intravascular Coagulation)。
弥散性血管内凝血是一种常见、复杂的凝血病理过程,其发病机制涉及凝血、纤溶、炎症和血管功能失调等多个方面。
DIC的特征是在全身性血栓形成的同时,伴有纤维蛋白溶解亢进和血小板减少。
DIC常见于其他疾病的并发症中,如严重感染、创伤、癌症等,特别是在严重感染中发生率较高。
DIC的主要病理生理特征是血栓在血管内形成,同时纤溶功能亢进。
血栓在血管内形成导致机体微循环障碍,特别是毛细血管内形成小血栓时,容易引起组织缺血、缺氧和器官功能损害。
纤溶功能亢进使纤维蛋白溶解过多,导致机体出现广泛纤溶症状,如出血、凝血功能障碍等。
DIC的临床表现多样,主要表现为出血、栓塞和器官功能障碍。
出血主要包括皮肤、黏膜、内脏器官等多种部位的明显或隐性出血。
栓塞可导致肺栓塞、脑栓塞等严重并发症。
器官功能障碍常见于伴发DIC的严重感染患者,如肾脏功能损害、肝功能损害等。
DIC的诊断主要依靠临床表现和实验室检查。
临床症状和体征有助于初步判断患者是否存在DIC,并可进一步明确病情严重程度。
实验室检查包括血液凝血功能指标和纤溶功能指标的检测。
常用的指标包括凝血酶原时间、活化部分凝血活酶时间、纤维蛋白原、D二聚体、血小板计数等。
DIC的治疗要根据病因和发病机制进行综合治疗。
一般而言,治疗DIC的原则是纠正病因、控制炎症、抑制凝血、调节纤溶等。
对于具体的病因,如感染、创伤等,需针对性地进行治疗。
对于炎症反应亢进和血小板减少的患者,可应用抗炎症药物及输注血小板。
对于纤溶功能亢进的患者,可应用纤溶抑制剂进行控制。
总之,DIC是一种常见且复杂的凝血病理过程,其发病机制涉及凝血、纤溶、炎症和血管功能失调等多个方面。
对于DIC 的治疗,需根据具体病因和发病机制进行综合治疗,以达到控制病情和预防并发症的目的。
dic指标
DIC指标是一种广泛应用于血液凝血功能监测领域的指标,它是凝血
酶原时间(PT)和活化部分凝血活酶时间(APTT)两个海绵体外凝血时间
测定结果的总和。
DIC指标是病理生理过程中凝血与纤溶紊乱的综合体现,常用于评估重症患者凝血功能紊乱的程度和预后等情况。
DIC指标异常与众多严重疾病密切关联,例如感染性休克、多发性创伤、心肺复苏等引起机体脏器灌注障碍的疾病。
这些疾病往往会触发机体
的凝血功能和纤溶功能紊乱,导致DIC指标的异常。
DIC指标的异常通常
会伴随着血栓形成、微循环障碍、血小板减少等一系列严重病理生理反应,对患者预后产生不良影响。
除了在临床中评估重症患者的凝血功能紊乱情况,DIC指标还常用于
监测某些病因不明的出血病例。
此时,医生会通过检测DIC指标的变化来
判断是否存在凝血功能障碍。
当DIC指标升高时,意味着机体纤维蛋白溶
解系统的激活程度较高,出现了大量的血小板减少和微血栓形成,从而导
致出血症状加重。
总之,DIC指标是一种重要而广泛应用的检测手段,它可以帮助医生
及时发现和评估患者的凝血功能紊乱情况,指导合理的治疗方案和监测疗效。
因此,对于临床医生来说,熟练掌握DIC指标的检测方法和临床应用,对于提高重症患者的救治效果具有重要意义。
弥散性血管内凝血(DIC)
概念:由于某些致病因子作用,凝血因子和血小板被激活,大量促凝物质入血,凝血酶增加,进而微循环中形成广泛的微血栓。
DIC的特征:广泛微血栓形成、凝血功能障碍
凝血功能障碍的特征:先高凝后低凝
临床表现:出血、休克、器官功能障碍、溶血性贫血
一、DIC的原因和发病机制
引起DIC的原因很多,最常见的是感染性疾病。
DIC可以由单一因素或同时由多种原因引起。
其始动环节是凝血系统激活引起广泛微血栓形成。
(一)、DIC常见原因:
感染性疾病革兰氏阴性或阳性菌感染、败血症等;
病毒感染如病毒性肝炎等
肿瘤性疾病肝癌、白血病、子宫癌、胃癌等
妇产科疾病流产、妊娠中毒症、子宫破裂等
创伤及手术严重软组织创伤、大面积烧伤等
1、凝血系统
凝血过程三个阶段:
内凝途径/外凝途径-→凝血活酶形成(Ⅹa、Ⅴ、PL、Ca2+)-→凝血酶生成-→纤维蛋白生成
●凝血活酶形成的作用:
●反馈性加速凝血酶原向凝血酶的转化;
●诱导血小板的不可逆聚集;
●激活Ⅻ、ⅩIII;
●激活纤溶酶原,增强纤溶系统活性
(1)内源性凝血系统:血管内皮损伤-→接触胶原-→各种凝血因子
(2)外源性凝血系统:组织损伤-→组织因子-→各种凝血因子
共同途径是形成:凝血酶原激活物-→凝血酶原-→凝血酶-→纤维蛋白原-→纤维蛋白-→交联纤维蛋白凝块
2、抗凝血系统
(1)体液抗凝:组织因子途径抑制物,抗凝血酶Ⅲ,蛋白C系统,纤维蛋白溶解系统
(2)细胞抗凝:单核巨噬细胞,肝细胞
纤维蛋白降解产物:
纤溶酶具有广泛的丝氨酸水解酶活性,能水解凝血终产物纤维蛋白生成可溶性的纤维蛋白降解产物,也能水解纤维蛋白原和其他多种凝血因子、血浆蛋白与组织蛋白。
(二)DIC的发生机制
1.组织因子释放,启动凝血系统
组织损伤(创伤、产科意外等)、肿瘤组织坏死、白血病细胞破坏
可释放大量组织因子(TF)入血+Ca2++F Ⅶ
凝血酶原激活物
凝血酶
促进DIC发生
常见于:
1).产科意外:约占DIC病例的8.6~20%
见于:羊水栓塞、胎盘早剥、宫内死胎等。
其中羊水栓塞最为常见。
2).外科手术及外伤:约占12.7~15%
见于:胃、肠、肾脏、胆道等手术,大面积烧伤,挤压综合征
3).肿瘤组织大量破坏:约占20-28.3%
多发生于癌肿晚期,临床表现以慢性型为主。
可见于前列腺、肺、肾、乳腺、胰腺、胆道等癌肿,以广泛转移者诱发DIC。
4).感染性疾病
2.血管内皮细胞损伤,启动凝血系统:缺氧、酸中毒
3.血细胞大量破坏,血小板被激活
(1)、血小板的激活
1)血小板表面糖蛋白(GPIb)与假血友病因子(vWF)结合(粘附)。
2)胶原、ADP、凝血酶等可激活血小板,释放ADP、凝血酶敏感蛋白等又进一步激活血小板。
3)活化的血小板可使膜糖蛋白GPⅡb/Ⅲa复合物被激活。
4)GPⅡb/Ⅲa作为血小板膜上的纤维蛋白原受体与纤维蛋白原结合(聚集)。
5)活化血小板表面出现带负电荷磷脂并通过Ca2+与含有γ-羧基谷氨酸的凝血因子(凝血酶原、Ⅹ、Ⅸ、Ⅶ)结合,凝血酶增多。
(2)、红细胞的大量破坏:异型输血、疟疾
(3)、白细胞破坏或激活:早幼粒细胞白血病放疗或化疗
4.促凝物质进入血液
1)、急性坏死性胰腺炎时,大量胰蛋白酶入血,激活凝血酶原。
2)、斑蝰蛇毒:含有两种促凝物质(Ⅴ、Ⅹ)
3)、锯麟蝰蛇毒:激活凝血酶原。
4)、羊水栓塞、转移瘤细胞等:激活凝血因子Ⅻ。
二、影响DIC发生发展的因素
1、单核巨噬细胞系统功能受损
单核巨噬细胞系统具有吞噬、清除凝血酶等促凝物质功能。
此功能障碍或吞噬大量坏死组织等时可引起DIC(全身性Shwartzman反应)。
2、肝功能严重障碍
许多活化的凝血因子是在肝脏灭活的,而且肝脏又是抗凝物质合成的主要场所。
因此肝功能严重障碍可促进发生DIC。
3、血液高凝状态
妊娠3周开始孕妇血液中血小板及凝血因子逐渐增多,纤溶系统功能低下,妊娠末期最明显,故产科意外时易发生DIC。
酸中毒是引起血液高凝状态的一个重要因素。
(原因:微血管内皮细胞受损;血小板的聚集性加强。
)
4、微循环障碍(休克晚期)
血液瘀滞,红细胞聚集,血小板粘附、聚集。
三、弥散性血管内凝血的分期和分型
分期:高凝期、消耗性低凝期、继发性纤溶亢进期
1、高凝期
由于凝血系统被激活,所以多数患者血中凝血酶含量增多,导致微血栓的形成,此时的表现以血液高凝状态为主。
2、消耗性低凝期
由于凝血系统被激活和微血栓形成,凝血因子和血小板因消耗而减少,此时常伴有继发纤溶。
所以有出血的表现。
3、继发性纤溶亢进
在凝血酶及因子XIIa的作用下,纤溶酶原活化素(激活物)被激活,从而使大量纤溶酶原变成纤溶酶,此时又有纤维蛋白(原)降解产物(FDP)的形成,它们均有很强的纤溶和(或)抗凝作用,所以此期出血十分明显。
四、DIC的功能代谢变化
出血、器官功能障碍、休克、贫血
(一)出血
出血是DIC患者最初的、最常见的临床现,也是诊断的一项重要依据。
特点:
1)发生率高;
2)出血原因不能用原发病解释;
3)出血形式多种多样;
4)普通止血药物治疗效果不佳。
出血的表现
⏹皮肤:出现瘀斑和紫癜
⏹消化道出血:呕血和黑便
⏹呼吸道:咯血
⏹泌尿生殖道:血尿、阴道出血
⏹黏膜:牙龈和鼻出血等
出血的机制
1 、凝血物质被消耗而减少
在DIC的发生、发展过程中,大量凝血因子和血小板被消耗,凝血物质减少,凝血功能障碍,导致出血。
2、纤溶系统激活
激活机制:
①继发于凝血因子Ⅻ的激活;
②子宫、肺、前列腺等组织坏死时释放组织纤溶酶原激活物,激活纤溶系统;
③应激时,肾上腺素使血管内皮细胞合成、释放纤溶酶原激活物增多;
④缺氧等原因使血管内皮细胞损伤,血管内皮细胞释放纤溶酶原激活物增多。
纤溶酶的作用:
降解纤维蛋白(原)产生纤维蛋白原)降解产物(FDP)。
水解凝血因子Ⅴ、Ⅷ、Ⅻa和凝血酶。
3、FDP的形成
FDP和FgDP分别是纤溶酶水解纤维蛋白和纤维蛋白原产生的具有抗凝作用可溶性多肽碎片。
作用:
1)、妨碍纤维蛋白单体聚合
2)、抗凝血酶
3)、多数碎片与血小板膜结合,降低血小板的粘附、聚集、释放功能
4.微血管壁的损伤
DIC的发生、发展过程中,各种原始病因和继发性引起的缺氧、酸中毒、细胞因
子和自由基等多种因素的作用,可导致微小血管管壁损伤。
(二)器官功能障碍
微血管中形成的微血栓,可阻塞相应部位的微循环血流,严重时可造成实质脏器的局灶性坏死,严重或持续过久的坏死性病变可成为受累脏器功能衰竭的原因。
累及肾上腺时可引起肾上腺皮质坏死,导致华-佛综合征;累及垂体发生坏死可致席汉综合征。
(三)休克
DIC,特别是急性DIC,常伴有休克。
重度及晚期休克又可促进DIC的形成,两者互为因果,形成恶性循环。
DIC引起休克的机制
1、微血管内大量微血栓形成回心血量减少;广泛出血使血容量减少;心肌损伤使心输出量减少。
2、DIC形成过程中产生大量血管活性物质,如激肽、补体成分、组胺等是微血管平滑肌舒张、通透性增加外周阻力降低,回心血量减少。
3、FDP的作用:某些成分可增强组胺和激肽的作用。
4、心功能降低:心、肺微血栓;缺血缺氧引起酸中毒;
(四)贫血-微血管病性溶血性贫血
性质:溶血性贫血
特征:外周血涂片可见某些形态特殊的红细胞,如盔形、星形和新月型、多角形、小球形等,统称为红细胞碎片。
DIC引起溶血性贫血机制
DIC时纤维蛋白丝在微血管腔内形成细网,当血流中的红细胞流过网孔时可粘着、滞留或挂在纤维蛋白丝上,由于血流不断冲击可引起红细胞发生形态改变或破裂。
红细胞变形能力下降,脆性增加。
DIC防治原则
一、防治原发病
二、改善微循环 1.扩容 2.解痉 3.纠酸 4.抗血小板聚集
三、重建凝血、纤溶的动态平衡
1.抗凝疗法
⑴肝素①指征:能迅速除去病因的DIC
②原则:宜早不宜晚
③剂量:遵循个体化原则
④慎用范围:DIC晚期继发纤亢、肝肾功能不全
⑵AT- Ⅲ
在肝素治疗开始后即刻用AT- Ⅲ,但在DIC后期伴继发纤亢时应慎用或不用。
2.DIC恢复期:酌情输新鲜血、或补充凝血因子、血小板。
患者,女,29岁。
因胎盘早期剥离急诊入院。
妊娠8个多月,昏迷,牙关紧闭,手足强直;眼球结膜有出血斑,身体多处有瘀点、瘀斑,消化道出血,血尿;血压10.64/6.65kPa(80/50mmHg),脉搏95次/分、细速;尿少。